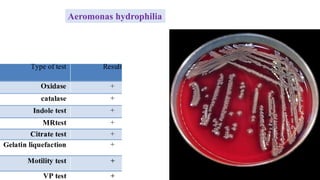
Aeromonas hydrophilia
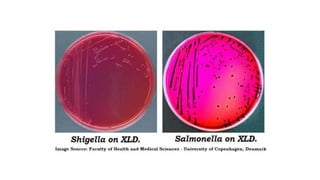
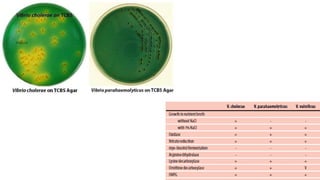
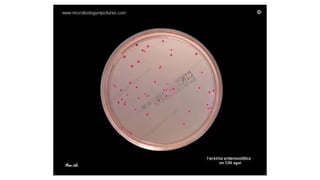
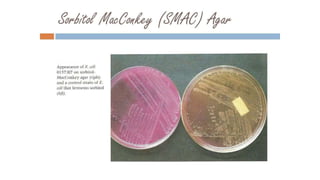
Food poisoning

Food poisoning is an illness resulting from consuming contaminated food, leading to symptoms like diarrhea and vomiting which affect millions annually. Various pathogens such as bacteria, viruses, and parasites are responsible for foodborne illnesses, with specific syndromes linked to different microorganisms. The document outlines the causes, symptoms, and implications of foodborne diseases, emphasizing the increasing cases attributed to lifestyle changes and food handling practices.
















![Foodborne Syndromes Caused by Microbial Agents or Their Toxins
Watery Diarrhea Without Fever Lasting 1 to 2 Days
The toxin binds to the apical membrane of epithelial tight junctions in the small
intestines, triggering
formation of pores influx and efflux of water, ions, and other small molecules
diarrhea and cytotoxicity.
B. cereus strains [elaborate two enterotoxins (hemolysin BL and nonhemolytic
enterotoxin) & enterotoxin (CytK)] (Long-incubation syndrome)
Diarrhea (96%),
Abdominal cramps (75%),
Vomiting (33%), and
Fever.
A foodborne infection (Necrotizing Enterocolitis), fatal in about 20% of patients,
is caused by C. perfringens type C in people with low protein intake; the disease is
rare outside of Papua New Guinea, where it is sometimes called pigbel.](https://image.slidesharecdn.com/foodpoisoning-210726080504/85/Food-poisoning-17-320.jpg)